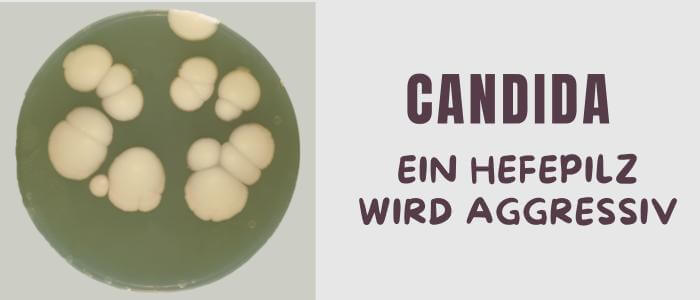

Der Hefepilz ist ein winzig kleines, nur mit dem Mikroskop erkennbares Lebewesen.
Wir alle kennen und schätzen die nützlichen Eigenschaften der Hefepilze, die bereits seit tausenden Jahren vom Menschen eingesetzt werden.
Sicherlich haben Sie selbst bereits davon Gebrauch gemacht, denn Backhefe, Bierhefe und Weinhefe ebenfalls Hefepilze.
Wir müssten auf viele leckere Lebensmittel, wie Brot, Pizza, Hefezopf, Stollen, Krapfen, aber auch Camembert, Bier oder Wein verzichten, wenn es den Hefepilz nicht gäbe.
Die meisten Hefepilze sind harmlos und richten keinen Schaden an.
Einige schwarze Schafe aus der Hefepilz-Familie sind jedoch gefährlich, sie können den Menschen und krankmachen.
Candida-Pilz – ein Hefepilz wird aggressiv
Hefepilze, die dem Menschen als unfreiwilligen Wirt schaden, indem sie im Körper dauerhaft überleben und ihn als lebende Futterquelle nutzen, werden pathogene Hefepilze genannt.
Die wichtigste, schädliche Hefepilz-Form wird „Candida“ genannt. Allein vom Candida-Pilz sind derzeit 17 Gattungen bekannt. Jede davon kann zu Erkrankungen beim Menschen führen.
Der „Candida albicans“ (übersetzt: weiße Hefe) ist wahrscheinlich die bekannteste Gattung, da er die meisten Hefepilzinfektionen verursacht.
Daneben existieren noch weitere schädliche Hefepilze, etwa der Candida tropicalis, Candida krusei, Candida famata und Candida glabrata.
Auch der Cryptococcus neoformans, der Blastoschizomyces capitatus, der Rhodotorula rubra, der Hansenula anomala und der Trichosporon beigelii Hefepilz können schwerwiegende Infektionen hervorrufen.
Der Hefepilz hat leichtes Spiel
Der Hefepilz liebt Zucker und durch den übermäßigen Verzehr von Zucker in unserer Gesellschaft, findet er paradiesische Verhältnisse im menschlichen Körper vor.
Zudem bewirken Antibiotika, dass die der natürlich Schutz durch die Darmflora gestört wird, wodurch diese uns nicht mehr so effektiv vor Pilzinfektionen schützen kann.
Menschen mit einem geschwächten Immunsystem, mit einem ungesunden Lebenswandel und Stress, sind besonders gefährdet, da sie dem Hefepilz zu wenig Abwehr entgegenbringen können.
Dadurch kann sich der Hefepilz unkontrolliert vermehren und den Wirt krankmachen. Er kann die Haut, die Schleimhäute und den Darm bevölkern.
Am besten gedeiht der Hefepilz in den feucht-warmen Regionen des Körpers, etwa in den Hautfalten, den Genitalien, in den Finger-und Zehen-Zwischenräumen, etc. Aber auch im Darm fühlt sich der Candida-Pilz besonders wohl.
Candida-Symptome
Es kann also nahezu jeder Bereich des Körpers vom Hefepilz befallen werden. Da die Candida-Symptome sehr unterschiedlich sind von Mensch zu Mensch, ist es ziemlich schwierig, diese als solche zu erkennen.
Dies ist dadurch bedingt, dass die Pilzinfektionen von unterschiedlichen Hefepilzen ausgelöst werden, zudem reagiert jeder Mensch anders auf einen Candida-Befall.
Deshalb können die Pilzerkrankungen innerhalb der Organe mit bakteriellen Infektionen verwechselt und dadurch falsch behandelt werden.
Die Hefepilzinfektion ist jedoch keine bakterielle Infektion und eine Antibiotika-Einnahme verschlimmert die Candida-Infektion statt sie mildern. Im schlimmsten Fall kommt es zum Versagen der betroffenen Organe.
Fazit:
Die beste Möglichkeit der Vorbeugung vor einer Hefepilzinfektion ist eine gesunde, ausgewogene Ernährung, regelmäßiger Sport, eine möglichst stressfreie Lebensweise und eine hygienische, saubere Umgebung.
Weitere Infos, Tipps und Hausmittel gegen den Candida albicans, sowie gegen Pilzinfektionen generell, gibt Ihnen Linda Allen in ihrem Ratgeber „Schluss mit Pilzinfekten“ >> Hier klicken*